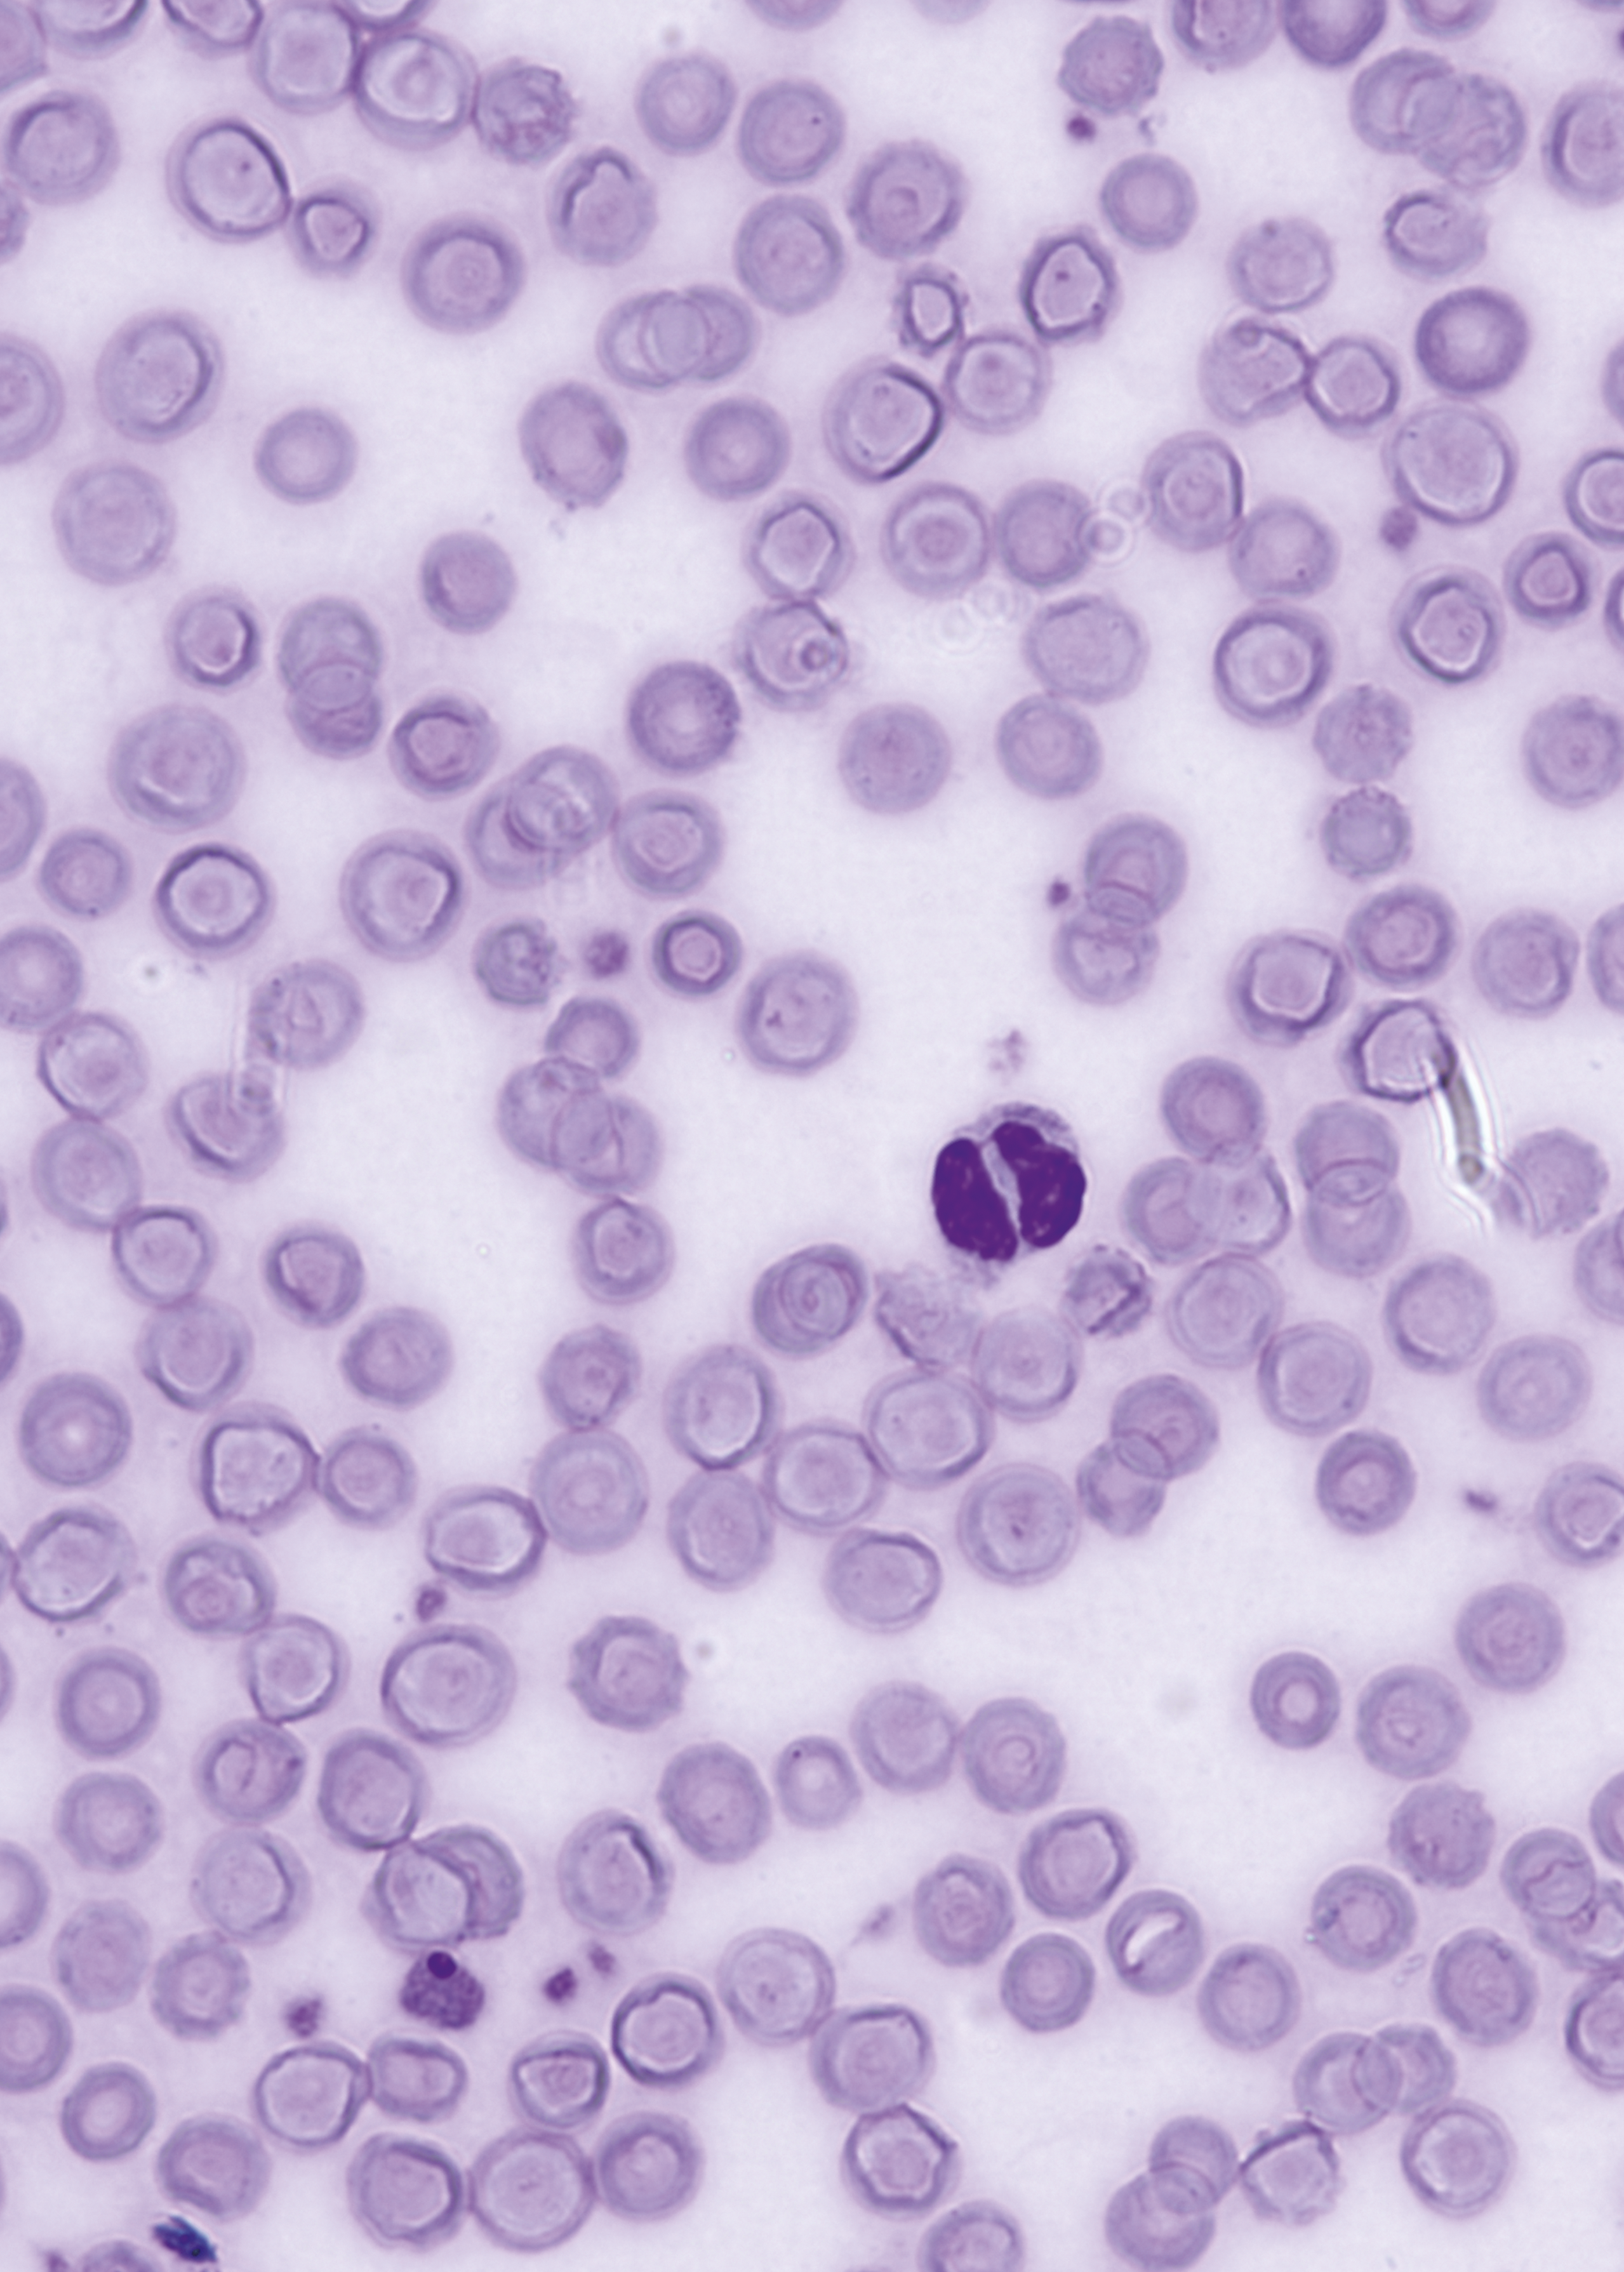
issue cover

Issue Archive
Table of Contents
BLOOD COMMENTARIES
PLENARY PAPER
Molecular patterns of response and treatment failure after frontline venetoclax combinations in older patients with AML
Clinical Trials & Observations
In this Plenary Paper, DiNardo and colleagues describe the molecular correlates of acute myeloid leukemia (AML) response and resistance to venetoclax in combination with hypomethylating agents or low-dose cytosine arabinoside. They identify specific response-modifier driver mutations that may be clinically applied to stratify patients in future trials or to inform selection of regimens in current practice.
HOW I TREAT
How I treat adults with advanced acute lymphoblastic leukemia eligible for CD19-targeted immunotherapy
Using 5 instructive real-life examples, Aldoss and Forman consider the advantages, limitations, and challenges of therapy with blinatumomab and anti-CD19 chimeric antigen receptor T cells for adult patients with relapsed or refractory B-lineage acute lymphoblastic leukemia. These insights should assist physicians and patients in making treatment decisions in 2020 while we await the outcomes of further clinical trials.
IMMUNOBIOLOGY AND IMMUNOTHERAPY
High-parametric evaluation of human invariant natural killer T cells to delineate heterogeneity in allo- and autoimmunity
Human invariant natural killer T cells (iNKTs) are a rare but heterogeneous innate-like lymphocyte population. The authors describe novel phenotypes of iNKTs and their distinct functions in acute graft-versus-host disease and autoimmunity.
Nivolumab treatment of relapsed/refractory Epstein-Barr virus–associated hemophagocytic lymphohistiocytosis in adults
Clinical Trials & Observations
Liu et al report exciting preliminary clinical data on the potentially curative role of immune checkpoint inhibition for the treatment of Epstein-Barr virus–associated hemophagocytic lymphohistiocytosis.
LYMPHOID NEOPLASIA
MYELOID NEOPLASIA
Dnmt3a loss and Idh2 neomorphic mutations mutually potentiate malignant hematopoiesis
How mutations in DNMT3a and IDH2 collaborate to generate myeloid malignancy has been a conundrum. Now Zhang and colleagues present transcriptomic, methylation, and metabolic profiling of murine myeloid cells with concurrent mutations and identify dependencies that may be amenable to therapeutic manipulation in patients.
THROMBOSIS AND HEMOSTASIS
Targeting myeloid-cell specific integrin α9β1 inhibits arterial thrombosis in mice
Brief Report
Dhanesha et al provide a novel insight into the role of neutrophils in arterial thrombus formation by showing that integrin α9β1 promotes neutrophil activation and neutrophil extracellular trap formation.
LETTERS TO BLOOD
Long-term outcomes of Sleeping Beauty–generated CD19-specific CAR T-cell therapy for relapsed-refractory B-cell lymphomas
Clinical Trials & Observations
High efficacy of venetoclax plus obinutuzumab in patients with complex karyotype and chronic lymphocytic leukemia
Clinical Trials & Observations
Co-occurrence of DNMT3A, NPM1, FLT3 mutations identifies a subset of acute myeloid leukemia with adverse prognosis
Clinical Trials & Observations
Ticagrelor causes false-negative functional tests for heparin-induced thrombocytopenia
Heparin-induced thrombocytopenia (HIT) occurs in 1-2% of patients with acute coronary events or cardiac surgery. Eekels and colleagues report that ticagrelor comedication must be taken into account by laboratory physicians for interpretation of functional tests for HIT, as the presence of the drug can cause false-negative results.
BLOOD WORK
ERRATUM
-
Cover Image
Cover Image
![issue cover]()
Pseudo–Pelger-Huët anomaly in the peripheral blood of Dnmt3a–/–;Idh2R140Q mice. See the article by Zhang et al on page 845.
- PDF Icon Front MatterFront Matter
- PDF Icon Table of ContentsTable of Contents
- PDF Icon Back MatterBack Matter
- PDF Icon Editorial BoardEditorial Board
Advertisement intended for health care professionals
Email alerts
Advertisement intended for health care professionals

BCL-2 inhibition and AML: can we best Darwin?